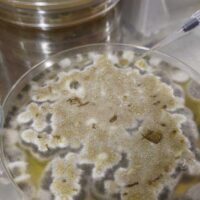

Kun kauppa ei kannata – yrittäjän turva vaikeina aikoina
Millainen on yrittäjän sosiaaliturva, kun firmalla ei menekään hyvin? Voiko yritystoimintaa jatkaessa saada tukea, että saa voita leivän päälle? Milloin…
YRITTÄJÄ, tule mukaan omiesi pariin! Liity Yrittäjiin.
JÄSEN, oletko jo ladannut Yrittäjät-sovelluksen puhelimeesi? Lataa sovellus Androidille tai Applelle.

Millainen on yrittäjän sosiaaliturva, kun firmalla ei menekään hyvin? Voiko yritystoimintaa jatkaessa saada tukea, että saa voita leivän päälle? Milloin…
Vaikka lääketieteessä ja teknologiassa otetaan jatkuvasti isoja harppauksia, sisäilman aiheuttamat oireilut ja sairastumiset eivät tunnu vähenevän. Pikemminkin sisäilmaongelmista tuntuu olevan…

Hyvinvointitapahtuma kaarinalaisille yrittäjille! Hikeä & Virtaa - yrittäjien hyvinvointitapahtuma 14.9. Hikeä & Virtaa - yrittäjien hyvinvointitapahtuma ti 14.9.2021 17:00 -…

Yrittäjyys vaatii kykyä kantaa vastuuta, sietää epävarmuutta ja keksiä ratkaisuja arjen haasteisiin. Koronan aiheuttama poikkeustilanne on kuitenkin pistänyt yritysten resilienssin…

Sähköavusteinen maastopyörä vei Toivakassa hostellia isännöivän Matti Tiaisen mennessään. Harrastus on vienyt ylimääräisiä kiloja ja parantanut arkista jaksamista.
Teimme tämän oppaan kertoaksemme, että sinun ei tarvitse sinnitellä kaiken keskellä yksin. Selviämme parhaiten ja varmimmin yhdessä! Tässä oppaassa keskitymme…

Julkaistu: 20.11.2016 | 14:21 Teksti ja kuva: Somero-lehti/Sauli Kaipainen Ihmisten elinikä pitenee. Samalla yhä useampi vanhenee omat hampaat suussaan.Hammasproteesien käyttäjämäärä…

Yritys, palkkatyö ja opinnot koronavuoden aikana on ollut paketti, jota Miia Luokkala on pyörittänyt tarkalla suunnittelulla. Vapaapäivä viikossa on ehdoton.

Onnistuuko tiimityö vaikka tiimin jäsenet ovat etänä? Miten huolehtia me-hengen ja yhteisöllisyyden säilymisestä? Etäisyys vaikuttaa vuorovaikutuksen määrään ja vähentää vapaamuotoista…

Nyt mietitään, miten työ hybridimallissa saadaan toimimaan. Monet kysymykset mietityttävät: miten asiat saadaan sujumaan, millaisia käytäntöjä pitäisi luoda, kuinka säilyttää…